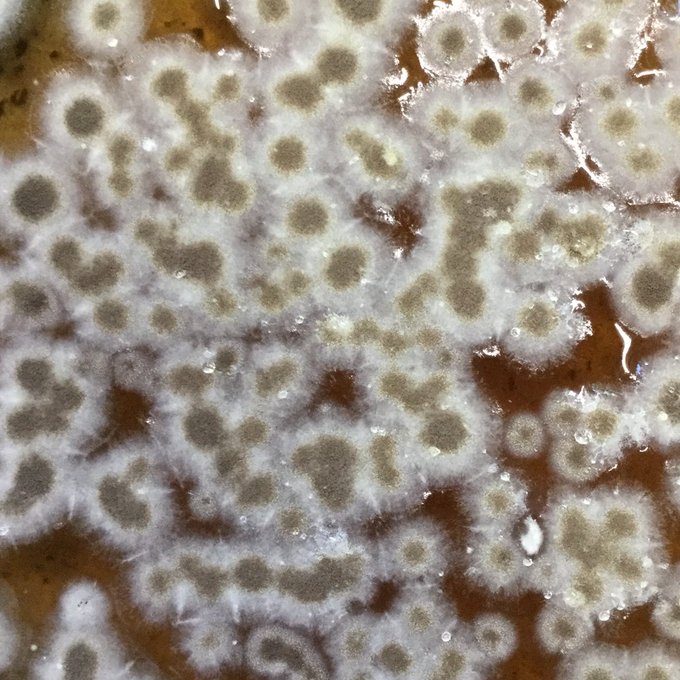

28 件中 1〜10件を表示
年に2度あるロックさんのお祭り的記念日
変な顔になっちゃった&日付けが変わってしまって間に合わなかったけど、おめでとうございます㊗️
#locke_fan
#超人ロック
この漫画は奇妙な服や格好いい服がいっぱいなのが良いですね
(どんなの着ててもシワがおかしくても未来の新素材だからいいんだよ)
4
16
昼間いただいたのにすっかり遅くなってしまったのだけど、侑香里さん(@murasakisya)が色を塗ってくださったのです!
お目目がキラキラでかわいいの!✨ありがとうございます✨
自分と違う塗り方が見れるの嬉しい😊 https://t.co/1weVX6mYF9
1
14
@murasakisya 見ましたよw ひとコマしかないんですね!
ポロの服ばっか描いてたせいでクセになって描き込んでしまったのでは…と思いました🤭
(あ、わし靴底描き忘れとる…orz)
2
4